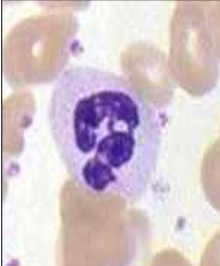
term image
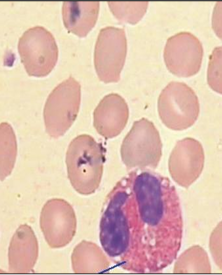
term image
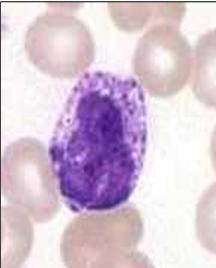
term image
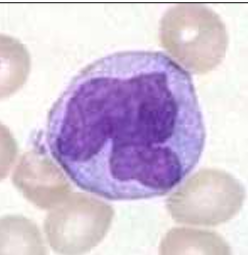
term image
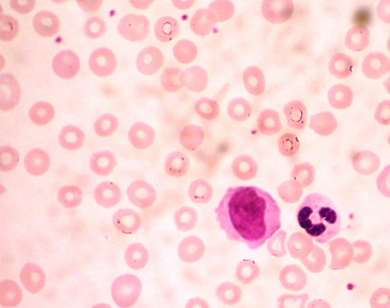
term image

1/47
Looks like no tags are added yet.
Name | Mastery | Learn | Test | Matching | Spaced | Call with Kai |
|---|
No analytics yet
Send a link to your students to track their progress
Sangre periférica
Qué es la sangre?
Tejido fluido que circula por capilares, venas y arterias de todos los vertebrados e invertebrados
Es un tejido especial compuesto por células (eritrocitos, glóbulos blancos y plaquetas) en un 45% y una sustancia intercelular líquida (plasma sanguíneo), en un 55%, en la cual están suspendidas las células


Trombocitos/plaquetas
Neutrófilo
Eosinófilo
Basófilo
Granulocitos


Neutrófilo en banda

Corpúsculo de Barr

Eosinófilo

Neutrófilo

Basófilo

Eosinófilo

Basófilo

Basófilo


Mastocitos

Mastocitos

linfocitos

Monocito

Linf B
Cómo se activan los linf B?


Cel. plasmática


Cel. plasmática

Cel. plasmática


Linf T

Linfocitos helper CD4+

LINFOCITOS NK y CITOTOXICIDAD CELULAR y NATURAL


linf NK
monocito

monocito
monocito
Qué es el Sistema Monocito–Macrofágico
Precursores médula ósea (monoblastos y promonocitos)
Monocitos circulantes
Macrófagos tisulares libres o fijos (histiocitos).
Células de Kuppfer (hígado)
Células revestimiento senos del bazo y ganglios linfáticos
Macrófagos alveolares del pulmón
Macrófagos libres líquido sinovial, pleural y peritoneal
Células dendríticas presentadoras de antígeno
Microglía del SNC
Células de Langerhans de la piel
Osteoclastos óseos
MÉDULA ÓSEA


MÉDULA ÓSEA

Médula ósea

Sinusoides medulares

Sinusoides medulares

Célula endotelial

Células reticulares

Células reticulares

Adipocitos



Macrófagos medulares
→ pocos y difíciles de ver

Células hematopoyéticas



Biopsia médula ósea
Valoración cantidad tejido hematopoyético/tejido adiposo

Extendido aspirado medular

Grupo medular
BIOPSIA MÉDULA OSEA Y ASPIRADO MEDULAR
